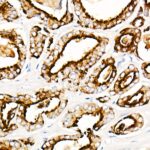

Prostatic Acid Phosphatase (PSAP) Rabbit mAb (A21195)
$148.00 – $548.00
Abclonal Prostatic Acid Phosphatase (PSAP) Rabbit mAb (Catalog Number: A21195) encodes an enzyme that catalyzes the conversion of orthophosphoric monoester to alcohol and orthophosphate.
- Details & Specifications
- References
| Catalog No. | A21195 |
|---|---|
| Product Name | Prostatic Acid Phosphatase (PSAP) Rabbit mAb (A21195) |
| Supplier Name | ABclonal, Inc. |
| Brand Name | Abclonal |
| Synonyms | ACPP; 5'-NT; ACP-3; TM-PAP |
| Gene Name | ACP3 |
| Protein Name | ACP3 |
| Uniprot/Swissprot ID | P15309 |
| Gene ID | 55 |
| Clone | ARC53079 |
| Clonality | Monoclonal |
| Source/Host | Rabbit |
| Reactivity | Human, Rat |
| Conjugate | Unconjugated |
| Note | Products will be shipped from the warehouse in Massachusetts. Promotion is running from time to time. Welcome to send a request for quote to message@sydlabs.com. |
| Order Offline | Syd Labs, Inc. 4 Avenue E, Hopkinton, MA 01748 USA. Phone: 1-617-401-8149 Fax: 1-617-606-5019 Email: message@sydlabs.com |
Description
A21195: Prostatic Acid Phosphatase (PSAP) Rabbit mAb
This gene encodes an enzyme that catalyzes the conversion of orthophosphoric monoester to alcohol and orthophosphate. It is synthesized under androgen regulation and is secreted by the epithelial cells of the prostate gland. An alternatively spliced transcript variant encoding a longer isoform has been found for this gene. This isoform contains a transmembrane domain and is localized in the plasma membrane-endosomal-lysosomal pathway.
Immunogen Information about Prostatic Acid Phosphatase (PSAP) Rabbit mAb (A21195)
Immunogen:Recombinant fusion protein containing a sequence corresponding to amino acids 33-386 of human Prostatic Acid Phosphatase (ACPP) (NP_001090.2).
Sequence:KELKFVTLVFRHGDRSPIDTFPTDPIKESSWPQGFGQLTQLGMEQHYELGEYIRKRYRKFLNESYKHEQVYIRSTDVDRTLMSAMTNLAALFPPEGVSIWNPILLWQPIPVHTVPLSEDQLLYLPFRNCPRFQELESETLKSEEFQKRLHPYKDFIATLGKLSGLHGQDLFGIWSKVYDPLYCESVHNFTLPSWATEDTMTKLRELSELSLLSLYGIHKQKEKSRLQGGVLVNEILNHMKRATQIPSYKKLIMYSAHDTTVSGLQMALDVYNGLLPPYASCHLTELYFEKGEYFVEMYYRNETQHEPYPLMLPGCSPSCPLERFAELVGPVIPQDWSTECMTTNSHQGTEDSTD
Gene ID:55
Swiss prot:P15309
Synonyms:ACPP; 5′-NT; ACP-3; TM-PAP; Prostatic Acid Phosphatase (PSAP)
Calculated MW:45kDa
Observed MW:50kDa
Images of Prostatic Acid Phosphatase (PSAP) Rabbit mAb (A21195)

Western blot analysis of extracts of Rat liver, using Prostatic Acid Phosphatase (ACPP) antibody (A21195) at1:1000 dilution.
Secondary antibody: HRP Goat Anti-Rabbit IgG (H+L) (AS014) at 1:10000 dilution.
Lysates/proteins: 25μg per lane.
Blocking buffer: 3% nonfat dry milk in TBST.
Detection: ECL Basic Kit (RM00020).
Exposure time: 90s.

Immunohistochemistry analysis of paraffin-embedded Human benign prostatic hyperplasia using Prostatic Acid Phosphatase (ACPP) Rabbit mAb (A21195) at dilution of 1:100 (40x lens).Perform high pressure antigen retrieval with 10 mM citrate buffer pH 6.0 before commencing with IHC staining protocol.

Immunohistochemistry analysis of paraffin-embedded human prostate cancer using Prostatic Acid Phosphatase (ACPP) Rabbit mAb (A21195) at dilution of 1:100 (40x lens).Perform high pressure antigen retrieval with 10 mM citrate buffer pH 6.0 before commencing with IHC staining protocol.
Please remember our product information: Prostatic Acid Phosphatase (PSAP) Rabbit mAb (Catalog Number: A21195) Abclonal